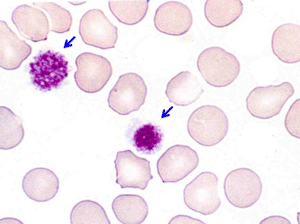
Plaquettes géantes

Sang normal - Normes
Sous le nom "d'hémogramme" (ou NFS) la nomenclature officielle comprend la numération des globules rouges, des globules blancs et des plaquettes, la formule leucocytaire, l'examen au microscope des globules rouges sur frottis, le dosage photométrique de l'hémoglobine, l'hématocrite et le calcul des constantes érythrocytaires. En cas d'anomalie d'un ou plusieurs de ces examens le laboratoire est habilité à compléter les investigations par une étude morphologique détaillée sur frottis des éléments figurés et un taux de réticulocytes.
La Numération-Formule Sanguine (NFS), ou hémogramme, est le reflet d'un grand nombre de mécanismes physio-pathologiques. Il est tout à fait justifié que la NFS soit l'un des examens biologiques les plus prescrits par les médecins praticiens.
Une règle fondamentale en hématologie est d'examiner systématiquement au microscope l'ensemble des éléments sanguins (hématies, leucocytes et plaquettes) dès qu'il existe une anomalie quantitative ou une alarme, quelle qu'elle soit, de la NFS obtenue par méthode automatique. A contrario l'examen du frottis sanguin n'a pas d'intérêt si la numération est normale et qu’aucune alarme n’est signalée.
La notion de "normalité" correspond à une définition statistique. Il s'agit de variables biologiques incluant 95% des individus "normaux", c'est à dire que ces normes excluent certains sujets pourtant bien portants et en incluent d'autres qui ne le sont point. Il convient de garder cette notion à l'esprit lorsqu'on interprète une NFS. Le résultat d'un hémogramme, comme de tout examen biologique, doit être replacé dans son contexte clinique par le médecin praticien. De plus certaines normes de la NFS varient légèrement avec le sexe, l'âge et la race.
À partir d’un travail personnel effectué au début des années 1980, nous proposons, dans le tableau ci-dessous, des normes établies sur une population de près de 1 200 personnes au travail, considérées comme indemnes de pathologies, comprenant près de 85% d’hommes. Elles ont été effectuées avec un automate de type Coulter® ne comportant pas de compteur de plaquettes, ni de formule automatique. Les chiffres indiqués correspondent à 2 écarts type par rapport à la moyenne.
Les normes généralement admises, telles que nous les donnerons ci-dessous, sont sensiblement différentes, mais elles ont été établies à partir de populations hospitalières. On doit donc rester très circonspect quant à la valeur de ces normes qui ont un intérêt plus opératoire que scientifique. Leur interprétation ne peut jamais être dissociée de l’environnement et des circonstances dans lesquelles elles ont été établies, à titre d’exemple un même chiffre de globules blancs peut être normal ou non selon la présence ou l’absence d’une fièvre.
1 - Les normes de la lignée érythrocytaire.
Le nombre d'hématies
Chez l'homme le nombre des hématies est de 4.000.000 à 5.700.000/µl, l'hématocrite de 40 à 53%, l'hémoglobine de 12,5 à 18 g/dl.
Chez la femme le nombre des hématies est de 3.800.000 à 5.300.000/µl, l'hématocrite de 36 à 50%, l'hémoglobine de 12 à 16 g/dl.
Les chiffres du nouveau-né sont supérieurs à ces normes : hématies supérieures à 5.500.000/µl, hématocrite supérieur à 50%, hémoglobine en rapport. Les chiffres de l'enfant sont au contraire plutôt plus bas que ceux de l'adulte et ce jusqu'à l'adolescence. Chez le vieillard la quantité d'hématies et d'hémoglobine tend à diminuer progressivement, ceci étant dû à la diminution de la masse médullaire active.
Les constantes érythrocytaires
Elles varient peu avec l'âge et le sexe.
Le volume globulaire moyen (VGM = Ht/GR) est de 85 à 100 µm3. Une valeur inférieure à 85 µm3 caractérise la microcytose, une valeur supérieure à 100 µm3 caractérise la macrocytose.
La teneur globulaire moyenne (TGM = Hb/GR) est de 27 à 33 µµg. Une valeur inférieure caractérise l'hypochromie, une valeur supérieure va toujours de pair avec une macrocytose car le globule rouge ne peut être sursaturé en hémoglobine.
La concentration globulaire moyenne (CGM = TGM/VGM = Hb/Ht) s'exprime en pourcentage et doit être supérieure à 32%. Une valeur inférieure traduit une désaturation de l'hématie en hémoglobine, donc une hypochromie.
Le taux de réticulocytes, déterminé par coloration spéciale, se situe entre 20.000 et 100.000/µl (0,5 à 2% des hématies). Les réticulocytes sont des globules rouges jeunes venant juste de quitter la moelle osseuse. Leur augmentation traduit donc une régénération médullaire.
Des anomalies morphologiques des hématies doivent être systématiquement recherchées et signalées par le laboratoire dès que la numération des hématies ou l'hémoglobine sont anormales. Ces anomalies peuvent être diverses :
- Anomalies de taille et de couleur : anisocytose, microcytose, macrocytose, hypochromie, parfois polychromatophilie.
- Anomalies de forme : poïkylocytose (variabilité des formes), annulocytose (hématies vides réduites à un anneau), dacryocytose (hématies en forme de larmes, de poires, de gouttes), schizocytose (hématies fragmentées, déchiquetées, anguleuses), acanthocytose ou échinocytose (hématies crénelées, en forme d'oursins qui sont habituellement des artefacts), hématies-cibles (en forme de cible de tir), sphérocytose (hématies denses et foncées, parfaitement sphériques), elliptocytose (hématies ovoïdes ou ovalocytes), drépanocytose (hématies en forme de faucille).
- Présence d'inclusions intra-érythrocytaires : spontanément visibles (corps de Jolly, anneaux de Cabot, ponctuations basophiles) ou demandant des colorations spéciales pour être mises en évidence (sidérocytes, corps de Heinz, hématies fœtales).
Dans certaines circonstances les hématies peuvent former des rouleaux (dysglobulinémies) ou s'agréger en amas (taux élevé d'agglutinines froides de faible amplitude thermique) rendant leur numération difficile voire impossible.
Il est très important que le médecin praticien tiennent compte de ces anomalies signalées par le laboratoire, certaines ont une grande spécificité et orientent vers un diagnostic précis : carence en fer devant des annulocytes, myélofibrose devant une dacryocytose, maladie de Moschcowitz devant une schizocytose, hémoglobinose-S devant des drépanocytes, anémie hémolytique devant des sphérocytes, antécédents de splénectomie devant des corps de Jolly, etc.
2 - Les normes des lignées leucocytaires.
Le taux des leucocytes est presque identique dans les deux sexes, compris entre 3.500 et 10.000/µl, tout juste un peu plus élevé chez l'homme que chez la femme. Il est un peu plus élevé encore chez le nouveau-né et le jeune enfant. Il tend à s'abaisser progressivement chez le vieillard pour la même raison que celle invoquée plus haut.
Le pourcentage des différentes catégories de leucocytes se situe dans les limites suivantes : polynucléaires neutrophiles 45 à 75%, polynucléaires éosinophiles 0 à 5%, polynucléaires basophiles 0 à 1%, lymphocytes 20 à 45%, monocytes 2 à 10%. Avec les appareils électroniques de comptage et formule automatique il n'est pas rare d'avoir des pourcentages égaux de polynucléaires et de lymphocytes.
Dans la prime enfance, et jusque vers 4 ans ou plus, le pourcentage des lymphocytes peut être supérieur à celui des polynucléaires. Chez les sujets de race noire existe une neutropénie physiologique, due à une hypermargination vasculaire, avec souvent moins de 30% de polynucléaires neutrophiles. Il ne doit pas apparaître dans la formule sanguine de leucocytes morphologiquement anormaux ni de précurseurs médullaires des polynucléaires. Avec les formules automatiques le pourcentage de cellules dites "indifférenciées" (LUC), c'est à dire non classables, ne doit pas excéder 2%.
Les chiffres absolus de leucocytes comptent en fait plus que les pourcentages et la notion "d'inversion de formule" n'a aucune signification et doit être bannie du vocabulaire médical. En effet l'augmentation d'un pourcentage ne peut se faire qu'aux dépens de la diminution d'un ou des autres. Ce qu'il importe de dégager de la formule leucocytaire c'est l'augmentation ou la diminution anormale d'une catégorie leucocytaire. Les chiffres absolus normaux, par microlitre (µl), se situent dans les limites suivantes:
- polynucléaires neutrophiles entre 2.000 et 7.500,
- polynucléaires éosinophiles moins de 500,
- polynucléaires basophiles moins de 100,
- lymphocytes entre 1.000 et 4.000,
- monocytes moins de 1.000.
Des anomalies cellulaires qualitatives et morphologiques des leucocytes doivent être systématiquement recherchées et signalées par le laboratoire en cas d'anomalie quantitative des leucocytes. Ces anomalies peuvent être diverses :
Anomalies morphologiques du cytoplasme ou du noyau des polynucléaires : granulations toxiques ou au contraire dégranulation, polynucléaires hypersegmentés, anomalies congénitales (nucléaires ou cytoplasmiques) du polynucléaire telles que l'anomalie de Pelger, les corps de Döhle, les anomalies d'Alder, de Chediak, de May-Hegglin. L'anomalie nucléaire de Pelger (absence de lobulation) peut être acquise et s'observe au cours des myélodysplasies primitives ou secondaires à des chimiothérapies.
Myélémie, définie par la présence dans le sang de cellules médullaires précurseurs des polynucléaires et parfois des hématies (érythromyélémie). Il faut noter à ce propos que si les érythroblastes passent en grand nombre dans le sang ils seront comptés par les automates comme des leucocytes, puisqu'il s'agit d'éléments nucléés, une correction devra donc être apportée pour calculer le chiffre réel de leucocytes circulants. La myélémie peut porter sur les précurseurs médullaires les plus jeunes et être faite d'éléments indifférenciés, dits "blastes", stigmates de leucémie aiguë.
Anomalies morphologiques acquises des lymphocytes caractéristiques de certaines maladies : immunoblastes des réactions immunitaires, tricholeucocytes, cellules de Sézary, lymphocytes granuleux.
Dans certains états pathologiques il peut être intéressant de demander au laboratoire une "formule d'Arneth". Celle-ci consiste à classer les polynucléaires neutrophiles observés sur le frottis coloré selon le nombre de lobes de leur noyau. Normalement on trouve moins de 5% de polynucléaires à un lobe, de 10 à 30% à deux lobes, de 40 à 50% à trois lobes, de 10 à 20% à quatre lobes et pratiquement pas de polynucléaires neutrophiles à cinq lobes ou plus. Toute déviation de cette formule vers la gauche traduit un rajeunissement de la lignée granuleuse et va généralement de pair avec une myélémie, correspondant à un besoin accru de granuleux et à une régénération médullaire ; toute déviation vers la droite traduit un vieillissement de la lignée et un blocage de la synthèse de l'ADN, généralement par carence vitaminique.
3 – Les normes de la lignée plaquettaire
Le taux de plaquettes sanguines normal se situe entre 120.000 et 450.000/µl et ne varie guère en fonction du sexe et de l'âge.
Une agglutination plaquettaire peut se produire chez certains sujets, par ailleurs normaux, en présence de l'anticoagulant contenu dans le tube de prélèvement sanguin (généralement de l'EDTA). La numération des plaquettes donne alors un chiffre par défaut qui fait conclure à tort à une thrombopénie. Il faut donc toujours contrôler en cas de doute le chiffre de plaquettes établi par le compteur de particules par l'examen cytologique du frottis coloré qui visualise les amas plaquettaires. S'il y a divergence un nouveau prélèvement doit être fait sur citrate ou par la technique dite de "l'Unopette".
Des anomalies morphologiques des plaquettes peuvent être observées sur le frottis coloré, notamment des plaquettes géantes.